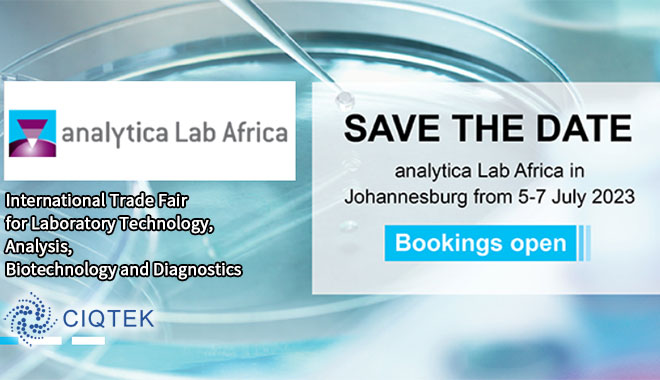
CIQTEK at Analytica Lab Africa 2023, Johannesburg, South Africa

- Field Emission Scanning Electron Microscope manufacturer global supplier
- SEM EDX, EDS, EBSD, BSE, CL, STEM detectors
- scanning nv magnetometer applications
- scanning nv center microscope
- scanning nv magnetometry supplier
- x band electron paramagnetic resonance spectroscopy
- electron paramagnetic resonance spectroscopy
- epr spectroscopy with cryostat
- w band epr spectrometer
- epr technology